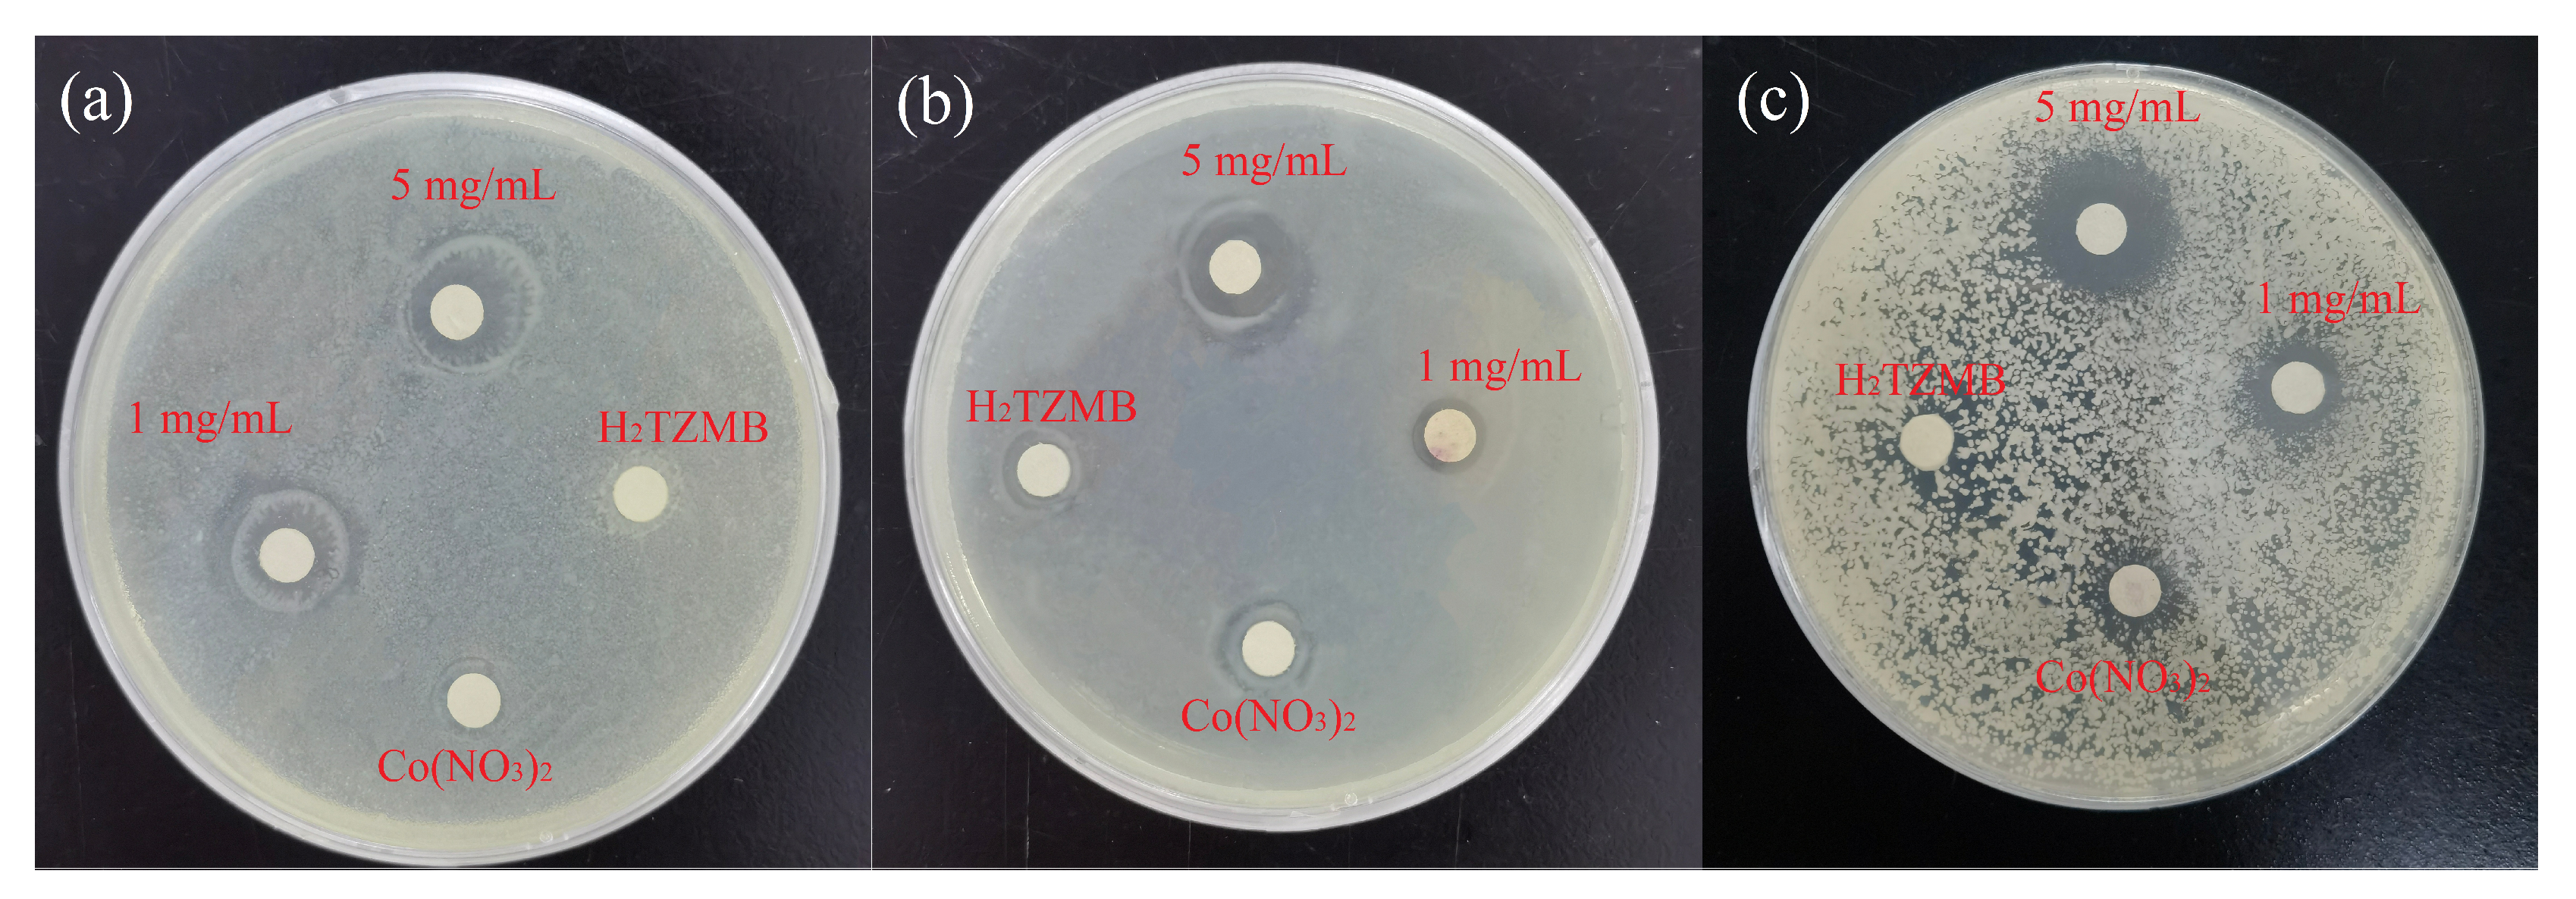
Molecules 28 05204 g004 Molecules 28 05204 g004

Application of a Mixed-Ligand Metal–Organic Framework in Photocatalytic CO2 Reduction, Antibacterial Activity and Dye Adsorption
Abstract
1. Introduction
2. Results and Discussion
2.1. Photocatalytic CO2 Reduction
2.2. Antibacterial Properties
2.3. Dye Adsorption
3. Materials and Methods
3.1. Materials and Instrumentation
3.2. Synthesis of MOF
3.3. Powder X-ray Diffraction (PXRD)
3.4. Optimum Reaction Conditions of Photocatalysis
3.5. Bacterial Incubation and Bacteriostatic Circle Experiment
3.6. MIC Determination and Growth Curve Experiment
4. Conclusions
Supplementary Materials
Author Contributions
Funding
Informed Consent Statement
Data Availability Statement
Conflicts of Interest
Sample Availability
References
- Hu, T.P.; Li, M.M.; Huang, Y.R.; Gao, L.L.; Wang, X.Q.; Gao, J.F.; Niu, X.Y. Fluorescent and magnetic properties of three complexes based on 4,4’ -(1H-1,2,4-triazol-1-yl)methylene-bis(benzonic acid). Polyhedron 2018, 151, 306–312. [Google Scholar] [CrossRef]
- Pettinari, C.; Pettinari, R.; Nicola, C.D.; Tombesi, A.; Scuri, S.; Marchetti, F. Antimicrobial MOFs. Coord. Chem. Rev. 2021, 446, 214121. [Google Scholar] [CrossRef]
- Gordillo, M.A.; Benavides, P.A.; Ma, K.; Saha, S. Transforming an Insulating Metal–Organic Framework (MOF) into Semiconducting MOF/Gold Nanoparticle (AuNP) and MOF/Polymer/AuNP Composites to Gain Electrical Conductivity. ACS Appl. Nano Mater. 2022, 10, 13912–13920. [Google Scholar] [CrossRef]
- Tarasi, S.; Ramazani, A.; Morsali, A.; Hu, M.L.; Ghafghazi, S.; Tarasi, R.; Ahmadi, Y. Drug Delivery Using Hydrophilic Metal–Organic Frameworks (MOFs): Effect of Structure Properties of MOFs on Biological Behavior of Carriers. Inorg. Chem. 2022, 33, 13125–13132. [Google Scholar] [CrossRef]
- Dai, F.N.; Wang, X.K.; Zheng, S.H.; Sun, J.P.; Huang, Z.D.; Xu, B.; Fan, L.L.; Wang, R.M.; Sun, D.F.; Wu, Z.S. Toward high-performance and flexible all-solid-state micro-supercapacitors: MOF bulk vs. MOF nanosheets. Chem. Eng. J. 2021, 413, 127520. [Google Scholar] [CrossRef]
- Zhu, X.; Yamamoto, A.; Imai, S.; Tanaka, A.; Kominami, H.; Yoshida, H. A silver–manganese dual co-catalyst for selective reduction of carbon dioxide into carbon monoxide over a potassium hexatitanate photocatalyst with water. Chem. Commun. 2019, 55, 13514. [Google Scholar] [CrossRef]
- Li, D.D.; Kassymova, M.; Cai, X.C.; Zang, S.Q.; Jiang, H.L. Photocatalytic CO2 reduction over metal-organic framework-based materials. Coord. Chem. Rev. 2020, 412, 213262. [Google Scholar] [CrossRef]
- Zhang, W.X.; Huang, R.T.; Song, L.Y.; Shi, X.Y. Cobalt-based metal–organic frameworks for the photocatalytic reduction of carbon dioxide. Nanoscale 2021, 13, 9075–9090. [Google Scholar] [CrossRef]
- Cui, Y.; Ge, P.X.; Chen, M.D.; Xu, L.L. Research Progress in Semiconductor Materials with Application in the Photocatalytic Reduction of CO2. Catalysts 2022, 12, 372. [Google Scholar] [CrossRef]
- Chen, Y.; Wang, D.K.; Deng, X.Y.; Li, Z.H. Metal–organic frameworks (MOFs) for photocatalytic CO2 reduction. Catal. Sci. Technol. 2017, 7, 4893–4904. [Google Scholar] [CrossRef]
- Han, Z.; Fu, Y.M.; Zhang, Y.C.; Zhang, X.; Meng, X.; Zhou, Z.Y.; Su, Z.M. Metal–organic framework (MOF) composite materials for photocatalytic CO2 reduction under visible light. Dalton Trans. 2021, 50, 3186–3192. [Google Scholar] [CrossRef]
- Zhang, W.X.; Yu, Y.; Huang, R.T.; Shi, X.Y. Efficient Photocatalytic Reduction of CO2 to CO Using NiFe2O4@N/C/SnO2 Derived from FeNi Metal–Organic Framework. ACS Appl. Mater. Interfaces 2021, 34, 40571–40581. [Google Scholar] [CrossRef]
- Lottie, B.; Astrid, K.L.; Michael, G.; Matthew, J.B.; David, W.D. The global incidence and diagnosis of fungal keratitis. Lancet Infect. Dis. 2021, 21, e49–e57. [Google Scholar]
- Liu, Y.W.; Zhou, L.Y.; Dong, Y.; Wang, R.; Pan, Y.; Zhuang, S.Z.; Liu, D.; Liu, J.Q. Recent developments on MOF-based platforms for antibacterial therapy. RSC Med. Chem. 2021, 12, 915–928. [Google Scholar] [CrossRef]
- Khan, Z.A.; Goda, E.S.; Rehman, A.U.; Sohail, M. Selective antimicrobial and antibiofilm activity of metal–organic framework NH2-MIL-125 against Staphylococcus aureus. Mater. Sci. Eng. B 2021, 269, 115146. [Google Scholar] [CrossRef]
- Ghaffar, I.; Imran, M.; Perveen, S.; Kanwal, T.; Saifullah, S.; Bertino, M.F.; Ehrhardt, C.J.; Yadavalli, V.K.; Shah, M.R. Synthesis of chitosan coated metal organic frameworks (MOFs) for increasing vancomycin bactericidal potentials against resistant S. aureus strain. Mater. Sci. Eng. C 2019, 105, 110111. [Google Scholar] [CrossRef]
- Li, X.Q.; Zhao, X.S.; Chu, D.D.; Zhu, X.L.; Xue, B.L.; Chen, H.; Zhou, Z.; Li, J.G. Silver nanoparticle-decorated 2D Co-TCPP MOF nanosheets for synergistic photodynamic and silver ion antibacterial. Surf. Interfaces 2022, 33, 102247. [Google Scholar] [CrossRef]
- Chen, J.Y.; Cheng, F.; Luo, D.W.; Huang, J.F.; Yang, J.F.; Nezamzadeh-Ejhieh, A.; Khan, M.S.; Liu, J.Q.; Peng, Y.Q. Recent advances in Ti-based MOFs in biomedical applications. Dalton Trans. 2022, 51, 14817–14832. [Google Scholar] [CrossRef]
- Lu, X.Y.; Ye, J.W.; Zhang, D.K.; Xie, R.X.; Bogale, R.F.; Sun, Y.; Zhao, L.M.; Zhao, Q.; Ning, G.L. Silver carboxylate metal–organic frameworks with highly antibacterial activity and biocompatibility. J. Inorg. Biochem. 2014, 138, 114–121. [Google Scholar] [CrossRef]
- Shams, S.; Ahmad, W.; Memon, A.H.; Shams, S.; Wei, Y.; Yuan, Q.P.; Liang, H. Cu/H3BTC MOF as a potential antibacterial therapeutic agent against Staphylococcus aureus and Escherichia coli. New J. Chem. 2020, 44, 17671–17678. [Google Scholar] [CrossRef]
- Mojdeh, N.; Kamran, A.; Mona, K.; Anukorn, P. Antibacterial activity of three zinc-terephthalate MOFs and its relation to their structural features. Inorg. Chim. Acta 2021, 522, 120353. [Google Scholar]
- Alguacil, F.J.; López, F.A. Organic Dyes versus Adsorption Processing. Molecules 2021, 26, 5440. [Google Scholar] [CrossRef] [PubMed]
- Guan, Y.b.; Cao, W.C.; Guan, H.X.; Lei, X.H.; Wang, X.H.; Tu, Y.Z.; Marchetti, A.; Kong, X.Q. A novel polyalcohol-coated hydroxyapatite for the fast adsorption of organic dyes. Colloids Surf. A 2018, 548, 85–91. [Google Scholar] [CrossRef]
- Hu, G.S.; Cui, G.; Zhao, J.; Han, M.Y.; Zou, R.Y. Pyrazine-cored covalent organic frameworks for efficient CO2 adsorption and removal of organic dyes. Polym. Chem. 2022, 13, 3827–3832. [Google Scholar] [CrossRef]
- Li, Y.Z.; Wang, G.D.; Yang, H.Y.; Hou, L.; Wang, Y.Y.; Zhu, Z.H. Novel cage-like MOF for gas separation, CO2 conversion and selective adsorption of an organic dye. Inorg. Chem. Front. 2020, 7, 746–755. [Google Scholar] [CrossRef]
- Mariyam, A.; Shahid, M.; Mantasha, I.; Khan, M.S.; Ahmad, M.S. Tetrazole Based Porous Metal Organic Framework (MOF): Topological Analysis and Dye Adsorption Properties. J. Inorg. Organomet. Polym. Mater. 2020, 30, 1935–1943. [Google Scholar] [CrossRef]
- Mir, N.U.D.; Ahmad, M.S.; Khan, S.; Khan, M.Y.; Vakil, F.; Saraswat, S.; Shahid, M. Simpler is better: A heterometallic (Mn-Na) metal organic framework (MOF) with a rare myc topology synthesized from bench chemicals for selective adsorption and separation of organic dyes. Inorg. Chem. Commun. 2022, 146, 110046. [Google Scholar]
- Raza, H.; Yildiz, I.; Yasmeen, F.; Munawar, K.S.; Ashfaq, M.; Abbas, M.; Ahmed, M.; Younus, H.A.; Zhang, S.G.; Ahmad, N. Synthesis of a 2D copper(II)-carboxylate framework having ultrafast adsorption of organic dyes. J. Colloid Interface Sci. 2021, 602, 43–54. [Google Scholar] [CrossRef]
- Liu, Y.; Qiu, G.Y.; Liu, Y.F.; Niu, Y.Z.; Qu, R.J.; Ji, C.N.; Wang, Y.; Zhang, Y.; Sun, C.M. Fabrication of CoFe-MOF materials by different methods and adsorption properties for Congo red. J. Mol. Liq. 2022, 360, 119405. [Google Scholar] [CrossRef]
- Farhad, A.; Rahman, M.; Salman, A.; Atefeh, S.; Mashallah, R.; Hossein, M.; Tejraj, M.A.; Mohammad, A. Superior chemical stability of UiO-66 metal-organic frameworks (MOFs) for selective dye adsorption. Chem. Eng. J. 2020, 399, 125346. [Google Scholar]
- Kumar, P.; Bansal, V.; Kim, K.H.; Kwon, E.E. Metal-organic frameworks (MOFs) as futuristic options for wastewater treatment. J. Ind. Eng. Chem. 2018, 3807, 16. [Google Scholar] [CrossRef]
- Zhan, X.Q.; Tsai, F.C.; Xie, L.; Zhang, K.D.; Liu, H.L.; Ma, N.; Shi, D.; Jiang, T. Ligands-Coordinated Zr-Based MOF for Wastewater Treatment. Nanomaterials 2018, 8, 655. [Google Scholar] [CrossRef]

| Entry | (MOF) mg | [{Ru(bpy)3}2+] mg | TEOA mL | CO μmol/g/h |
|---|---|---|---|---|
| 1 | 10 | 30 | 1 | 1757.53 |
| 2 | 0 | 30 | 1 | 167.37 |
| 3 | 10 | 0 | 1 | 4.13 |
| 4 | 10 | 30 | 0 | 6.59 |
| 5 a | 10 | 30 | 1 | 0 |
| 6 b | 10 | 30 | 1 | 0 |
Disclaimer/Publisher’s Note: The statements, opinions and data contained in all publications are solely those of the individual author(s) and contributor(s) and not of MDPI and/or the editor(s). MDPI and/or the editor(s) disclaim responsibility for any injury to people or property resulting from any ideas, methods, instructions or products referred to in the content. |
© 2023 by the authors. Licensee MDPI, Basel, Switzerland. This article is an open access article distributed under the terms and conditions of the Creative Commons Attribution (CC BY) license (https://creativecommons.org/licenses/by/4.0/).
Share and Cite
Jing, H.; Zhao, L.; Song, G.; Li, J.; Wang, Z.; Han, Y.; Wang, Z. Application of a Mixed-Ligand Metal–Organic Framework in Photocatalytic CO2 Reduction, Antibacterial Activity and Dye Adsorption. Molecules 2023, 28, 5204. https://doi.org/10.3390/molecules28135204
Jing H, Zhao L, Song G, Li J, Wang Z, Han Y, Wang Z. Application of a Mixed-Ligand Metal–Organic Framework in Photocatalytic CO2 Reduction, Antibacterial Activity and Dye Adsorption. Molecules. 2023; 28(13):5204. https://doi.org/10.3390/molecules28135204
Chicago/Turabian StyleJing, Hongwei, Lun Zhao, Guanying Song, Jiayu Li, Ziyun Wang, Yue Han, and Zhexin Wang. 2023. "Application of a Mixed-Ligand Metal–Organic Framework in Photocatalytic CO2 Reduction, Antibacterial Activity and Dye Adsorption" Molecules 28, no. 13: 5204. https://doi.org/10.3390/molecules28135204
APA StyleJing, H., Zhao, L., Song, G., Li, J., Wang, Z., Han, Y., & Wang, Z. (2023). Application of a Mixed-Ligand Metal–Organic Framework in Photocatalytic CO2 Reduction, Antibacterial Activity and Dye Adsorption. Molecules, 28(13), 5204. https://doi.org/10.3390/molecules28135204

